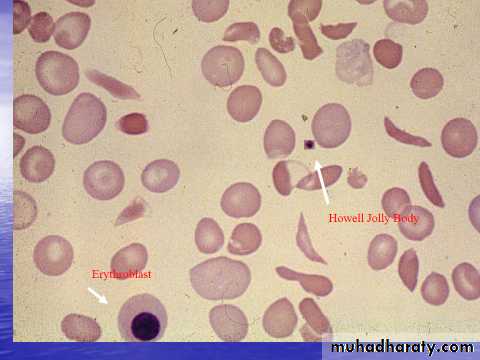

Fifth stage
MedicineLec-6
د.خالد نافع
18/10/2016
HEMOGLOBINOPATHIESHemoglobin Structure:
Hemoglobin transports oxygen to the tissues.
Each RBC contains hemoglobin.
A normal hemoglobin molecule consists of:
Four globin chains (2 alpha, 2 beta).
Each globin chain has an iron containing heme molecule.
The iron in the heme molecule binds to oxygen.
Genetics
In the first 8 weeks of embryonic life the predominant forms of hemoglobin are:Hb Gower 1 (ζ2ε2).
Hb Gower 2 (α2ε2).
Hb Portland 1 (ζ2γ2).
By the 12th week embryonic hemoglobin is replaced by Hb F (α2γ2) which represents 70 – 100% of hemoglobin in fetal life.
-Adult hemoglobin Hb A (α2β2) detectable from 16/40, replaces Hb F as predominant hemoglobin by 6/12 after birth, up to 30% of Hb in fetal life.
-Hemoglobin HbA2 (α2Δ2) is present in utero but only very minor in normal adults.
-In normal adults 96 – 98% of hemoglobin is HbA, Hb A2 (2 – 3%) and HbF (<1%) constitute a minor component of the total hemoglobin.
Geography
Commonest genetic defect world wide with an estimated 269 million carriers.90 million carriers in South East Asia, 85 million in Sub Saraharan Africa, and 48 million in the West Pacific region.
Distributed across South East Asia in a line stretching from Southern China down the Malaysian Peninsula to Indonesian islands.
Also distributed across the Mediterranean, Middle East, and Indian Subcontinent.
The distribution of the defect is thought to be due to partial protection for carriers from Plasmodium Falciparum Malaria.Electrophoresis
Electrophoresis is a means of separating hemoglobin's. It depends on the migration of the hemoglobin molecules dissolved in a buffer on, or in, a supporting medium when an electric current is passed through them.Principle of cellulose acetate
In an alkaline pH (8.2-8.6) Hb is a negatively charged molecule and will migrate toward the anode (+). The various Hbs moves at different rates depending on their net negative charge, which in turn is controlled by the composition (amino acids) of the Hb molecule (globin chain).
The red cell hemolysate (red blood cell membranes are destroyed to free the Hb molecules for testing) is placed in a cellulose acetate membrane, which is positioned in an electrophoresis tray with the inoculated hemolysate near the cathode (-).
Definition:Hemoglobinopathies are inherited disorders in which Mutation in or near the globin genes alter the structure of amino acid sequences or the rate of synthesis of a particular globin chain.Hb-S B6 glu valHb-C B6 glu lys
Defective hemoglobin
Sickle cell anemia:It results from single base change in the DNA coding for the amino acid in the sixth position in the b-globin chain.
This leads to an amino acid change from glutamic acid to valine HbS will be formed instead of the normal Hb.
INTRODUCTION
Sickle Cell Anemia is a hereditary disease which is cause by a disorder in the blood, a mutation in the Hemoglobin Beta Gene which can be found in the chromosome 11. This disease causes the body to make abnormally shapes red blood cells.A normal red blood cell is shaped as a round donut while the abnormal red blood cell has a “ C “ form.
Hb S is insoluble and forms crystals when exposed to low oxygen tension.
Deoxygenated sickle Hb polymerizes into long fibrils.
The red cells sickle may block the different areas of the microcirculation or large vessels causing infarcts of various organs.
It is widespread in Africa. Individuals with sickle-cell trait are relatively resistant to the lethal effects of falciparum malaria in early childhood.
Hemoglobin Beta Gene (HB-B) also known as Beta Globin is a protein that resides in the red blood cells.
The HBB is 146 amino acids long and its molecular weight is 15,867 Daltons.
The molecules of the hemoglobin are responsible to carry oxygen through the body.
The HBB is found in part 15.5 of the chromosome 11.
Pathophysiological effects of sickled cells1.Extravascular hemolysis .2. Loss of splenic function.3.Anaemia.4.Compromisation of the microcirculation.
CLINICAL MANIFESTATION1.complication from moderate to severe anemia2.slowed growth and development .3.cardiac over load leads to CHF .4.Bilirubin stones and cholecystitis .5.Aplastic crisis.
Sickle cell crisis.1.Splenic crisis (splenic sequestration syndrome, auto splenectomy)2.Infections.3.CNS and ophthalmic events (CVA, proliferative retinopathy).4.Acute chest syndrome (chromic pulmonary hypertension lead to cor-pulmonale).5.GIT : diffuse abdominal Pain.6.Genitourinary symptoms:- Painless haematuria.- hyposthenuia.- priapism.- hypogonadism.7.skeletal complication- hand-foot syndrome.- acute arthritis.- aseptic necrosis of the head of femur.- osteomyelitis .
8.Skin changes lead to chronic non-healing ulcer
DIAGNOSIS_Peripheral blood smears :sickled cells, target cells, Howell-Jolly bodies, normoblast, red cell fragment, increase platelet and occasionally leukocytosis._Screening test : sickling testThe presence of HbS can be demonstrated by exposing red cells to a reducing agent such as sodium dithionite; HbA gives a clear solution,whereas HbS polymerises to produce a turbid solution.
_Definitive diagnosis by
Hemoglobin electrophoresis (Hb-S = 87% , Hb-F = 9.7%, Hb-A2 = 3.3%)
Diagnosis of sickle cell anaemia Cont.Haemoglobin Electrophoresis:Hb A 0 %Hb S 87.0 %Hb F 9.7 %Hb A2 3.3 %Both parents of the affected individual will have sickle-cell trait
TREATMENTPainful vaso-occlusive crisis1.hydration2.precepitating factors3.oxygen therapy4.analgesic5.exchange transfusion*Antisickling agent (Hydroxyurea) increase Hb F reduce sickling.*Bone marrow transplantation(Allogeneic-BMT).* Gene therapy.Maintenance therapy and prevention1.folic acid 1 mg/d orally.2.pneumococcal vaccine.3.pregnancy (increase crisis, abortion, stillbirth) folate,, exchange transfusion. Exchange transfusion will increase Hb-A= 60%.4.general anesthesia; Careful hydration and oxygenation.*Angiographic contrast media causing sickling should be avoided
The thalassemia syndromes
Are inherited disorders arising from globin gene mutations that either reduce or totallyabolish the synthesis of one or more globin chains.These imbalance in chain synthesis lead to formation of unstable Hb. or decrease Hb. lead to hypochromic microcytic anaemia .The thalassaemia named according to globin chain involved.THALASSEMIAPathophysiology of thalassemia
α- thalassemia, gene deletions are responsible for the decrease or absence of α- chains.ß- thalassemia : usually due to an mRNA abnormality.This mutation reduces or eliminates the production of ß-globin chainsClinical manifestations of thalassemiaß- thalassemia major (ßoßo): is the most severe -Becomes apparent 3-6 months after birth when switch from Hb-F to Hb-A takes place :Hepatosplenomegaly (gall stones are also common )Expansion of the bones (hair on end appearance on skull X-ray examination).Severe anaemia with growth retardation and delayed sexual developmentDamage to heart, pancreas, endocrines and liver due to iron over load
Pathogenesis of anaemia of ß-thala.Decreased B- globin production has two major consequences :total Hb. synthesis is reduced leading tomicrocytic anaemia, low level of Hb-A lead to increase Hb-A2,Hb-F.free α-chain accumulates in the RBCα-chain accumulate and precipitate in RBC lead to hemolysis, destruction of RBC in the BM.
The extent to which ß-chain synthesis is suppressed determine the degree of anaemia (ineffective erythropoiesis)Extramedullary hematopoiesis and increased erythropoiesis in the BM lead to over all RBC production is increased due to accumalation of α chain.
DIAGNOSIS OF ß-THALASSAEMIAPositive family history with:a.non specific findings :Blood smear reveals microcytic RBCs, poikilocytosis, fragmented RBCs, MCV is low (around 65fl).Heinz bodies are evident by supravital stains.b. specific findings :Definitive diagnosis of ß-thala. Is based on the following findings on Hb. Electrophoresis :increased proportion of Hb-A2(> 3.5%).increased proportion of Hb-F.
α –thalassaemia
Decrease synthesis of a-chains, lead to precipitation of Hb-H (4-ß chains) or Hb- Bart’s (4 δ-chains)Classification of α –thalassaemia:1-Hydrops fetalis : severe, all 4 α -genes are deleted lead to severely anaemic, edematous,stillborn infant. Hb-barts (4 δ -chains had very high oxygen affinity).α-THALASSAEMIAS
2- HbH disease : deletion of 3 α –genes lead to unstable Hb. result in precipitationand extra-vascular hemolysis.3-α -thalassaemia Trait: deletion of 2 α genes.4-α-thalassaemia Carrier: deletion of 1 α gene, asymptomatic.
DIAGNOSIS OF α-THALAPositive family history with lab finding non specific findings :Blood smear show microcytic, hypochromic red cells, target cells, anisopoikilocytosis, and decrease MCV.Heinz bodies are evident.Specific findings : definitive diagnosis is finding of HbH by Hb electrophoresis.
Hb H Preparation
Hb H Preparation
Hb –H Diagnosis
Haemoglobin Electrophoresis:Hb A 91.5 %
Fast moving band 8.5%
Hb A2 and Hb F decreased
Hb H Preparation
TREATMENT OF α- AND ß- THALASSEMIA1.Regular red cell transfusions: hypertransfusion program (keep the level of Hb>110g/L)2.Neocytes transfusion (increase RBC survival, decrease frequency of transfusion, anddecrease iron over load).2-3 units every 4-6 weeks .3.Leukocyte filter will lowers rate of transfusion reaction.4.Folic acid supplementation (5 mg) to prevent aplastic crisis.5.Iron chelation:*Desferioxamine (Desferal) either with each unit of transfused blood (2 g) or by slowsubcutaneous daily infusions by pump (1-4g over 8-12) *(Exjade ) Deferasirox*Deferiprone6.Splenectomy ;indication: mechanical difficulty,hypersplenism.7.Bone Marrow Transplantation : prior to development of hepatomegaly, portal fibrosis &iron over load.
PRENATAL DIAGNOSIS OF THALASSAEMIAGuide parents and physicians in decidingwhether to complete pregnancy.Both parent carriers.Fetal diagnosis:fetoscope to sample fetal venous blood show α/ß chain synthesis ratio.Amniocentesis or trophoblast (chorionic villus) biopsy for DAN analysis using DNA probes.